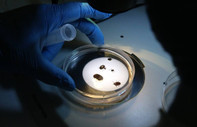
Kene mevsimi uzadı, uzmanlar önlem listesi verdi

"araştırma" ile ilgili içerikler

İnsanlık 1 milyon yıl önce doğmuş olabilir mi?
Çin’in Hubei eyaletinde ortaya çıkarılan 'Yunxian 2' adlı kafatası, Homo sapiens’in düşündüğümüzden en az yarım milyon yıl önce evrilmeye başlamış olabileceğini gösteriyor. Yeni araştırmaya göre bu bulgu, insan evrim tarihinin en kritik bölümlerinden birini değiştirebilir
26 Eylül 2025
Kene mevsimi uzadı, uzmanlar önlem listesi verdi
Uzmanlar, kenelerin artık daha erken ortaya çıktığını ve mevsimlerinin uzadığını söylüyor. Doğada vakit geçirenlere önlem çağrısı yapılıyor
28 Temmuz 2025
Yıllarca 'kopya' olarak sergilenen belge orijinal Magna Carta çıktı
Harvard Hukuk Fakültesi’nin 1946’da yalnızca 27,50 dolara satın aldığı ve yıllarca “kopya” sanılan Magna Carta belgesinin aslında 1300 yılına ait özgün bir metin olduğu ortaya çıktı. Uzmanlara göre bu tarihi belge, milyonlarca dolar değerinde olabilir
15 Mayıs 2025
Araştırma: Doğa ağrıyı hafifletiyor
Yeni yapılan bir araştırma, doğa belgeselleri ve doğal manzaraların izlenmesinin, ağrıyı hafifletici bir etki yaratabileceğini ortaya koydu
16 Mart 2025
Yalnızlık felç riskini artırabilir
Harvard Üniversitesi'nden bilim insanlarının yaptığı yeni bir araştırma uzun süreli yalnızlığın yaşlılarda felç riskini artırabileceğini ortaya koydu
25 Haziran 2024
Dinozorun son yemeği midesinden çıktı
2009 yılında Kanada'da bulunan dinozor fosili üzerinde yapılan araştırmada bir ilke rastlandı. 75 milyon yıllık fosilin yediği son yemek midesinde korunmuş halde bulundu. Dinozorun son yemeğinin içeriği bilim insanlarını şaşırtırken beslenme şekline dair ilk somut kanıt olma özelliği gösteriyor
10 Aralık 2023
Haftada dört gün mesai uzun vadede pek çok fayda sağlıyor
Kısaltılmış çalışma haftası üzerine yapılan yeni araştırma, iş-yaşam dengesi ve odaklanma için uzun vadeli faydalara işaret ediyor. Araştırmaya göre haftada dört gün mesai yapan çalışanların uzun vadede verimliliği önemli ölçüde artıyor, şirkete sağladıkları katma değer de yükseliyor
30 Temmuz 2023
Daha az içki ve sigara tüketmenize yardımcı olabilir
Hayvanlarla yapılan çalışmalara göre diyabet tedavisinde kullanılan GLP-1 etkili ilaçların beyinde bağımlılık davranışlarını değiştirdiği tespit edildi. Uzmanlar, gündemde olan Ozempic'in de aynı etkiyi yarattığını tahmin ediyor. ABD'de birçok üniversitede konuya dair araştırmalar başladı
19 Haziran 2023
Rüyalar neden tekrar eder?
Rüya araştırmacıları ve psikologlar, bazı insanlarından neden tekrar eden rüyalar gördüğünü araştırıyor. Dr. Alex Dimitriu, bu tip rüyaların insanlar için genel olarak rahatsız edici olduğunu belirtirken Deirdre Barrett, insanların birer parçası olduğunu söyledi
16 Nisan 2023
Yaşlandıkça kilo hedefiniz nasıl değişmeli?
40'lı, 50'li, 60'lı, 70'li yaşlarda kaç kilo olmalısınız? Yaşlandıkça vücut kompozisyonu ve enerji ihtiyaçları değişiyor. Peki her on yılda kilo hedefi olarak ne belirlenmeli? Uzmanlar, düşünülenin aksine yaşlandıkça vücut kitle endeksinin daha fazla olmasının bir sakıncası olmadığını söylüyor
16 Nisan 2023
Açık havada egzersiz yapmak neden daha faydalı?
Kanada'da bulunan Victoria Üniversitesi'nden araştırmacılar, açık alanda egzersiz yapmanın kapalı alana kıyasla daha faydalı olduğunu belirledi. Daha önce yapılan araştırmalarla birlikte yapılan incelemede, yeşillik bir alanda yürümenin nörolojik açıdan daha yararlı olduğu ortaya kondu
13 Nisan 2023
23 yıl sonra Apple'ın bilgisayar satışlarında en sert düşüş
Yüksek enflasyon ve resesyon endişeleriyle birlikte tüketiciler bilgisayarlara daha az talep gösterdi, küresel piyasalarda PC satışları eridi. Apple ise bu durumdan en çok etkilenen marka oldu. Şirketin PC satışları %40,5 oranında geriledi, 2000 yılının son üç ayından bu yana en sert düşüşünü yaşadı
10 Nisan 2023
Beethoven'ın sırları yüz yıllar sonra ortaya çıkıyor
Bilim insanları, tüm dünyanın yakından tanıdığı ve ardında unutulmaz eserler bırakan besteci Ludwig van Beethoven'ın sağlığı ve soyu hakkında daha fazla bilgi edinmek için saç tellerini kullandı
22 Mart 2023
Sosyalleşen memeliler daha fazla yaşıyor
Yalnızlık sadece morali değil, yaşam beklentisini de düşürüyor. Yapılan yeni bir araştırmaya göre sosyalleşmenin ömrü artırdığı tek memeli insan değil. 974 farklı türün incelenmesi ortak bir eğilimi gösterdi: Grup halinde yaşayan canlılar daha uzun yaşıyor
02 Şubat 2023
En iyi fikirler neden banyoda aklımıza gelir?
Bilim insanları iyi fikirlerin banyoda akla geldiği iddialarını araştırdı. Gerçekten de sıcak bir duşun sadece bedene değil zihne de iyi geldiği ispatlandı. Ancak yaratıcılık için duş etkisi yani buhar ve köpük şart değil. Washington Post duşa koşmak yerine kullanılabilecek 4 formülü yazdı
28 Ocak 2023
Harvardlı profesörlere göre mutlu olmanın 7 yolu
İki Harvard profesörünün yazdığı 'The Good Life' kitabı, dünyanın en uzun süreli mutluluk araştırmasının buldukları hakkında. 1938'de başlayan araştırmaya göre mutluluğun sırrı başarıda değil, kurduğunuz ilişkilerde. Buna ulaşmanın 7 yolu ise hem iş hayatınızdan, hem de sosyal medyadan geçiyor
22 Ocak 2023
İskoçya'da araştırıldı: Yunuslarda Alzheimer belirtilerine rastlandı
İskoçyalı bilim insanları ülkede bulunan üç farklı yunus türünde yaptıkları incelemede, beyinlerinde Alzheimer'ın ilk aşamalarında görülerin belirtilere rastladılar
23 Aralık 2022
Düşük karbonhidratlı ve hayvansal gıdalarla beslenme tip 2 diyabet riskini artırabilir
Amerikan Kalp Derneği tarafından yürütülen çalışmada, düşük karbonhidratlı ve hayvansal gıdalarla beslenmenin tip 2 diyabet riskini artırabileceği saptandı
19 Kasım 2022
İnsanlar 780 bin yıl önce pişmiş gıda tüketmeye başlamış olabilir
Son yapılan araştırma, insanların 780 bin yıl önce ateş kullanarak pişmiş besin tüketmeye başlamış olabileceğine işaret ediyor. Öte yandan bilim insanları, çiğ besin tüketiminden pişirmeye geçişin, insanın gelişimi ve davranışında kritik etkilerinin olduğunu düşünüyor
16 Kasım 2022
B3 vitamini meme kanseri ve beyin metastazı riskini artırıyor
ABD'de yapılan bir araştırmada, B3 vitamini takviyesinin meme kanseri ve beyin metastazı gibi ciddi hastalık risklerini artırdığı ortaya çıktı. Araştırmanın gelecekte kemoterapi gibi kanser tedavilerini geliştirmeye yardımcı olabileceği belirtildi
15 Kasım 2022
5 saatten az uyuyanlar risk altında
Yapılan bir çalışmada 50 yaşın üzerindeki insanların 5 saatin altında uyumasının sağlık risklerini artırdığı ortaya çıktı. 25 yıl boyunca incelenen 50 yaş üstü katılımcılarda birden fazla eş zamanlı kronik rahatsızlıkların oluştuğu tespit edildi
26 Ekim 2022
Eski sevgilinizi unutamıyorsanız bir de bu yöntemi deneyin
Learning & Memory dergisinde yayınlanan yeni bir çalışmada uyku esnasında belli sesleri dinlemenin kötü anıları unutmanıza yardımcı olabileceği ortaya çıktı. Öte yandan bu sesler, bazı anıları daha güçlü hatırlamanızı da sağlayabilir
18 Ekim 2022
İnsanlar kendilerini neden gıdıklayamaz?
Gıdıklama her zaman ciddi bir konu olarak görülmez ancak yeni bir çalışma bunların beyinle ilgili temel soruları nasıl ele alabileceğini gösteriyor. Çalışmada öne çıkan ilk şey kendi kendini gıdıklamanın diğer kişinin gıdıklanmasını yüzde 25 oranında azalttığı
16 Ekim 2022
Erkekler biyolojik olarak kadınlardan hızlı yaşlanıyor
Finlandiya'da Jyvaskyla Üniversitesi’nde yapılan araştırma, erkeklerin biyolojik olarak kadınlardan daha hızlı yaşlandığını ortaya koydu
11 Ekim 2022






